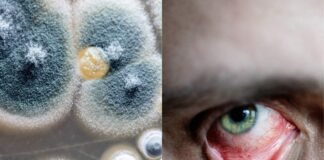
किसी भी मेडिकल कॉलेज में ब्लैक फंगस के मरीजकरवा सकते हैं इलाज

Tag: पीजीआई रोहतक
कोरोना की तीसरी का डर, दवाओं का बफर स्टाक करने के...
रोहतक। पंडित भगवत दयाल पोस्ट ग्रेजुएट इंस्टीट्यूट आफ मेडिकल साइंस (पीजीआई) में दवाओं का बफर स्टाक करने के लिए निर्देश जारी कर दिए गए...
किसी भी मेडिकल कॉलेज में ब्लैक फंगस के मरीजकरवा सकते हैं...
रोहतक। देश भर में कोरोना के साथ -साथ ब्लैक फंगस जैसी घातक बीमारी भी आ चुकी है। जिसने सबका जीना हराम कर रखा है।...
जींद में स्वास्थ्य विभाग का छापा, भ्रूण व एमटीपी किट बरामद
जींद। जींद जिले के गांव बेरीखेड़ा में गर्भवती महिला द्वारा गर्भपात करवाए जाने की सूचना मिलने पर स्वास्थ्य विभाग की टीम ने छापेमारी की।...
कोरोना वायरस को लेकर पीजीआई में राज्य स्तरीय बैठक
रोहतक। कोरोना संक्रमण को लेकर पीजीआईएमएस रोहतक में वीडियो कॉन्फ्रेंसिंग के जरिए राज्य स्तरीय बैठक का आयोजन हुआ। इस बैठक में मेडिकल एजुकेशन डिपार्टमेंट,...
पीजीआई ने बताए 252 डेंगू मरीज, जबकि स्वास्थ्य विभाग कह रहा...
रोहतक। जिले में डेंगू से पीडि़त मरीजों की संख्या बढ़ती जा रही है। जिला स्वास्थ्य विभाग ने डेंगू के 138 मरीज होने की बात...
दिल के मरीजों को 80 फीसद तक सस्ती मिलेंगी दवाइयां-उपकरण
रोहतक। पीजीआई रोहतक में आने वाले मरीजों के लिए राहत भरी खबर है। यहां की कैथ लैब में दिल संबंधी रोग के इलाज के...
पीजीआई रोहतक में शुरू होगा डीएनबी कोर्स, बढ़ेगी स्पेशलिस्ट की संख्या
रोहतक। पंडित भगवत दयाल शर्मा स्वास्थ्य विज्ञान विश्वविद्यालय के कुलपति डॉ. ओ.पी. कालरा ने कहा कि भारत में चिकित्सा क्षेत्र में स्पेशलिस्ट चिकित्सकों की...
पीजीआई रोहतक में आर्गन ट्रांसप्लांट की कवायद शुरू
रोहतक। पंडित भगवत दयाल शर्मा स्वास्थ्य विज्ञान विश्वविद्यालय में जल्द ही आर्गन ट्रांसप्लांट शुरू किया जा सकेगा। कुलपति डॉ. ओ.पी. कालरा का कहना है...
पीजीआई रोहतक की डॉ. मोहिनी को मिला ‘बेस्ट ओरल पेपर अवॉर्ड’
रोहतक। पंडित भगवत दयाल शर्मा स्वास्थ्य विज्ञान विश्वविद्यालय के मेडिसन विभाग की एसोसिएट प्रो. डॉ. मोहिनी को बेस्ट ओरल पेपर अवार्ड से नवाजा गया...
पीजीआई रोहतक के निलंबित निदेशक को बिना जांच किया बहाल
रोहतक। फार्मा कंपनी के खर्चे पर विदेश में सैर करने के दोषी पाए गए पीजीआई रोहतक के निदेशक पद पर तैनात डॉक्टर नित्यानंद को...